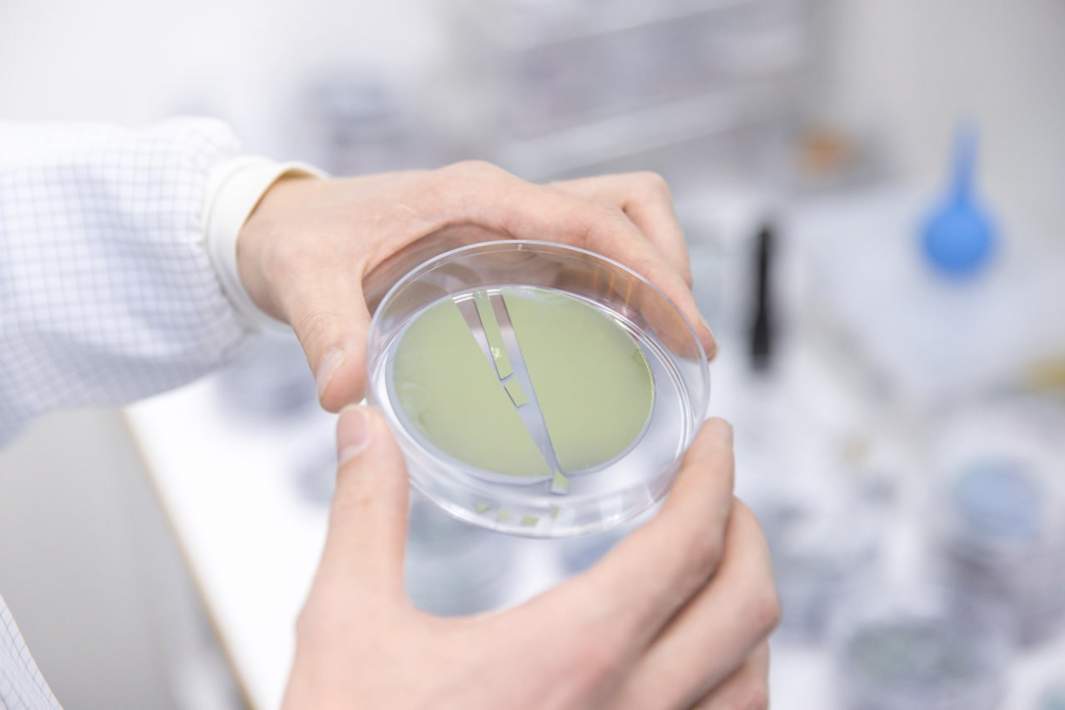
Фотография выращенных нанопроводов на Si подложке

- Статьи
- Science and technology
- Not without a wire: experts have taught cells to reproduce "alien" DNA
Not without a wire: experts have taught cells to reproduce "alien" DNA

Russian scientists have developed a technology that makes it possible to use a cell to produce any desired protein, even if there is no data about it in its DNA. For this purpose, they use the thinnest nanowires, which pierce the cell membrane and a molecule with hereditary information penetrates the resulting holes. The nanowires change the spectrum of their luminescence depending on the processes occurring in the cell, which is valuable for the creation of sensitive biosensors. According to experts, the discovery can be used to produce drugs and various sensors, but further research is needed to begin practical application.
How cells produce the necessary proteins
Specialists from Peter the Great St. Petersburg Polytechnic University (SPbPU) and Academic University have developed a technology for delivering DNA into cells using so-called nanowires. These are the thinnest filamentous nanocrystals of semiconductor compounds, which due to their unique geometry are able to penetrate the cell membrane. Through the resulting hole plasmid - a ring molecule of nucleic acid - enters the cell, and the cell begins to produce the alien protein encoded in it. Scientists call this process transfection. The technique can be used to produce medicines.
- The original idea was to create a system for transfection - the delivery of nucleic acids - into cells. For modern life sciences, transfection is one of the most important tasks, because it makes it possible to force cells to synthesize not only those proteins that are embedded in their DNA, but also any other, arbitrary proteins. Thus, on the one hand, it is possible to study the effect of turning on or off certain processes on the cell or even the whole organism, and on the other hand- to obtain in large quantities of the necessary proteins, such as monoclonal antibodies, widely used in the therapy of various diseases- said senior researcher at the Academic University Stanislav Shmakov.
The researchers developed a system in which an array of nanowires is formed on the surface of a multi-well tablet, and DNA can be added directly into the wells, without prior manipulation.
However, after experimentally confirming the possibility of transfection, the scientists discovered another unexpected effect during their research. Interacting with the cell, nanowires over time change the spectrum of fluorescence, which opens the possibility of creating a variety of sensors. As explained by experts, filamentous nanocrystals are primarily optically active structures. They are able to shine brightly, so they are convenient to measure the optical signal. They can also be used to measure electrical parameters such as potential or current.
- There are several potential applications of this system as a biosensor. First, we found a significant shift in the luminescence spectrum of nanowires in the presence of living cells. That is, they can be used as sterility detectors. Even a small presence of living cells can change the optical properties of nanowires. This can be utilized in various biotechnological applications. Secondly, the change in the spectrum is associated with certain biochemical reactions related to cell metabolism. This means that such systems can be used to measure the level of cell metabolism under different conditions," said Ivan Mukhin, chief researcher at the Research Laboratory of Epitaxial Nanostructures of A3B5 Compounds on Silicon at SPbPU.
Since nanowires are semiconductor structures, they can be easily connected to measuring devices and investigate changes in the electrical potential of cells, which remains an important task for studying neurons, the specialist added.
Biosensors from nanowires
As explained to "Izvestia" senior researcher at the Institute of Immunology and Physiology of the Ural Branch of the Russian Academy of Sciences Mikhail Bolkov, in the proposed methodology, hereditary information is transferred to the cell with the help of plasmids. These are such molecules that bacteria use to exchange DNA among themselves. And geneticists use this property for their own purposes. The idea is that nanotubes are grown on a special substrate, and cells are applied on top of them. As a result, the membranes are pierced, and the desired nucleic acid is placed there. It penetrates into the cell and the cell begins to produce the protein encoded in the plasmid. In this way it is possible to obtain means to fight genetic diseases, anemia and many other pathologies.
- Once inside the cell, the thin nanowires move to the nucleus and are destroyed. As a result, their luminescence spectrum changes, which can be used to develop biological sensors. However, to determine what exactly can be detected with their help, we need further research," he said.
According to Grigory Zyryanov, a professor of the Department of Organic and Biomolecular Chemistry at UrFU, nanowires can be of various lengths, starting from three molecules and more. They are usually made from organic or organic-inorganic semiconductors. The behavior of each organic molecule within such a wire can influence its behavior as a whole. While giving, for example, an electrical response or leading to a change in fluorescence.
- This happens when the nanowire is destroyed or its length changes due to biochemical reactions or simple mechanical effects. This is very promising for the purposes of biosensorics, localized temperature sensors, acidity level measurement, etc. Accordingly, connected to the cell such a molecular nanowire will give an intense response, reacting to events occurring inside, including biochemical processes, - he said.

Because of the nanoscale geometry of the wires can easily get inside the cell, absorbed by it. Moreover, the cell may not even be destroyed. Such a principle is used, for example, in cancer therapy, when nanoscale particles are targeted to the sick cell, and after external targeted action, such as the action of electromagnetic field, cause its death, the expert added.
The research was partially supported by the Russian Science Foundation.
Переведено сервисом «Яндекс Переводчик»